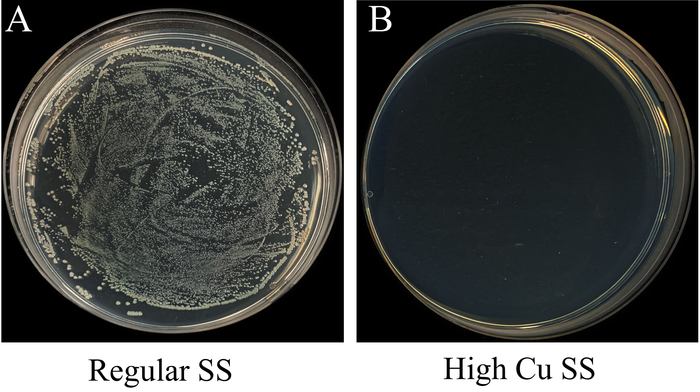

អ្នកវិទ្យាសាស្ដ្រហុងកុងមួយក្រុម បានបង្កើតដែកអ៊ីណុកថ្មីមួយប្រភេទ ដែលអាចធ្វើឱ្យមេរោគកូវីដ១៩ អសកម្មក្នុងរយៈពេលមិនប៉ុន្មានម៉ោង
យោងតាមការចុះផ្សាយរបស់សារព័ត៌មាន South China Morning Post បានរាយការណ៍ថា អ្នកជ្រាវជ្រាវមួយក្រុមមកពីទីក្រុងហុងកុង បានបង្កើតដែកអ៊ីណុកប្រភេទថ្មីមួយ ដែលអាចសម្លាប់មេរោគ COVID-19 លើផ្ទៃរបស់វា ក្នុងរយៈពេលប៉ុន្មានម៉ោងប៉ុណ្ណោះ។ វាត្រូវបានគេរំពឹងថា នឹងវាយលុកទីផ្សារក្នុងរយៈពេល ៦ខែ ខាងមុខនេះ ដោយវានឹងធ្វើការកាត់បន្ថយហានិភ័យនៃការឆ្លងមេរោគ ដែលនៅជាប់នឹងកូនសោទ្វារ ប៊ូតុងជណ្ដើរប្រអប់ និងកន្លែងមានការប៉ះពាល់ច្រើនផ្សេងទៀត។

វាគឺជាដែកថែបប្រឆាំងមេរោគ COVID-19 ដំបូងគេរបស់ពិភពលោក ជាមួយនឹងការរួមផ្សំរវាងទង់ដែង និងលោហធាតុ ដែលធ្វើឱ្យកោសិកាមេរោគ COVID-19 នឹងត្រូវអសកម្ម ៩៩.៧៥% នៅក្នុងរយៈពេល ៣ម៉ោង និង ៩៩.៩៩% ក្នុងរយៈពេល ៦ម៉ោង ខណៈដែលជាធម្មតាមេរោគ COVID-19 អាចនៅផ្ទៃខាងក្រៅបានរហូតដល់ ៣ថ្ងៃ យ៉ាងតិច នេះបើតាមការអះអាងរបស់សាស្ត្រាចារ្យ Huang Mingxin ពី នាយកដ្ឋានវិស្វកម្មមេកានិច នៅសាកលវិទ្យាល័យហុងកុង។ ប៉ាតង់មួយត្រូវបានគេដាក់ស្នើរ ហើយក្រុមរបស់លោក Huang កំពុងទាក់ទងជាមួយដៃគូឧស្សាហ៍កម្មថ្មីៗ ដើម្បីវាយលុយចូលទីផ្សារឱ្យបានលឿនបំផុត។
របកគំហើញនេះគឺជាលទ្ធផលនៃការសាកល្បងរយៈពេល ២ឆ្នាំ ដែលបានបង្ហាញថា ដែកអ៊ីណុកដែលមានសារធាតុទង់ដែងលើសពី ១០% មួយនេះ អាចធ្វើឱ្យមេរោគ COVID-19 អសកម្មទៅវិញបានយ៉ាងឆាប់រហ័ស នៅពេលដែលជាធម្មតាមេរោគ COVID-19 មានសមត្ថភាពអាចរស់បាននៅលើលោហៈផ្សេងទៀតក្នុងរយៈពេលយូរ។ ទោះបីជាយ៉ាងណាក៏ដោយ លោក Huang បាននិយាយថា ក្រុមរបស់លោកមិនទាន់បានធ្វើតេស្តវាប្រឆាំងនឹងមេរោគ COVID-19 បំប្លែងខ្លួនថ្មីនៅឡើយទេ ដោយកត់សម្គាល់ថា ការស្រាវជ្រាវរបស់លោកត្រូវបានធ្វើឡើងជាមួយនឹងមេរោគ COVID-19 ប្រភេទដើមប៉ុណ្ណោះ៕

អត្ថបទ៖ លីដា
ប្រភព៖ SCMP